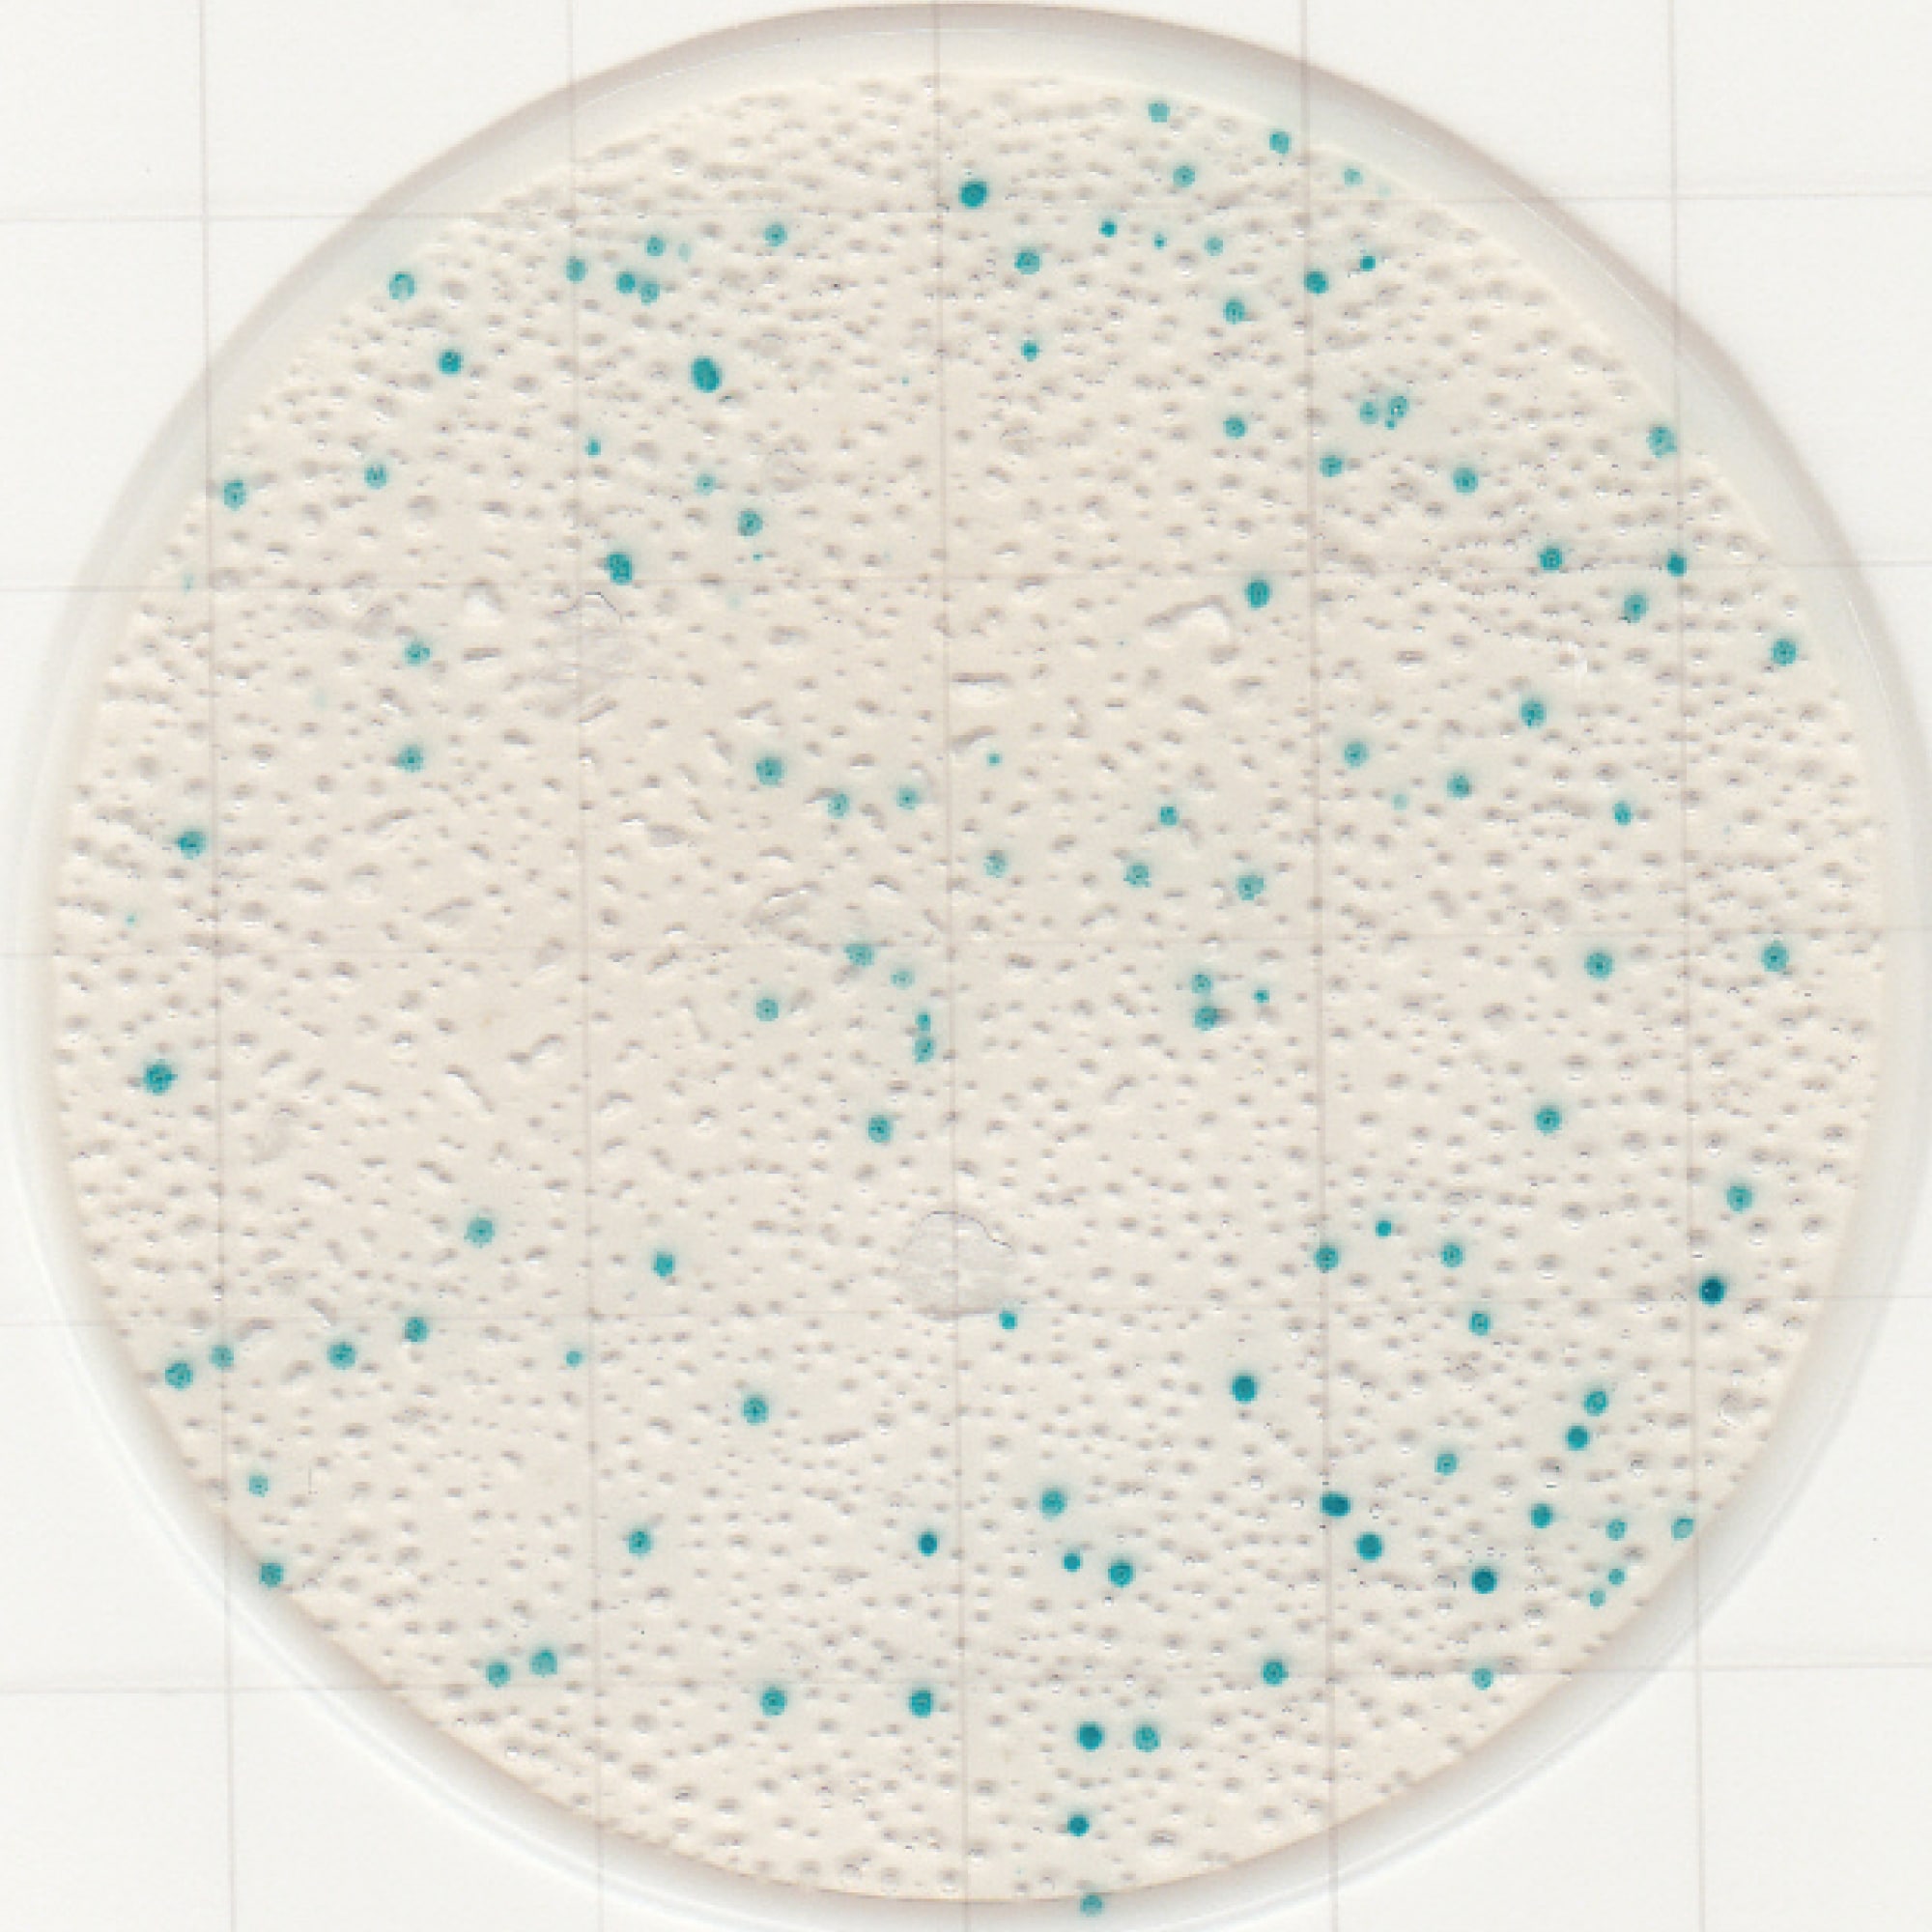

発色酵素基質X-Galにより、大腸菌群のコロニーを明瞭な青色に発色させ、検出するフィルム培地です。

発色酵素基質X-Galにより、大腸菌群のコロニーを明瞭な青色に発色させ、検出するフィルム培地です。
気泡の有無やコロニーの大きさを確認する必要がないため、寒天培地などの他の培地に比べ、コロニーの判別、カウントが容易です。

多種多様な食品で、寒天培地との高い相関性を確認しております。

AOAC PTM認証、MicroVal認証、NordVal認証を取得しています。 また、「食品衛生検査指針微生物編2018 ※」にも収載されております。
※「Medi・Ca」として収載されています。
※以下は発色の一例です。
※培養条件:35℃、24時間(希釈液:リン酸緩衝生理食塩水)
| Escherichia coli (NBRC 15034) |
Citrobacter freundii (NBRC 12681) |
Klebsiella pneumoniae (NBRC 14940) |
 |
 |
 |
| Enterobacter aerogenes (NBRC 13534) |
Enterobacter cloacae (NBRU 13536) |
Escherichia fergusonii (NBRC 102419) |
 |
 |
 |
| 鶏挽肉 | 豚挽肉 | 貝割れ大 |
 |
 |
|
| マグロ | クッキー+E. coli | 牛乳+K. pneumoniae |
 |
 |
 |
| 名称 | 内容 |
|---|---|
| キット構成 | 100枚(25枚×4袋) |
| 対象微生物 | 大腸菌群 |
| 培養温度 | 35±1℃ |
| 培養時間 | 24±1時間 |
| 未開封の保存条件 | 2~8℃ |
| 開封後の保存 | 開封後は袋の端を2回以上折り返してテープで止め、冷蔵保存(2-8℃)の上、3ヶ月以内に使用してください。 |
| 使用期限 | 製造から18ヶ月 |
| 認定/規定 | 食品衛生検査指針微生物編2018※ AOAC PTM認証取得 MicroVal認証取得 NordVal認証取得 |
| 測定回数 |
100回 |
| JANコード |
4549160985360 |
| 希望小売価格 |
※「Medi・Ca」として収載されています。